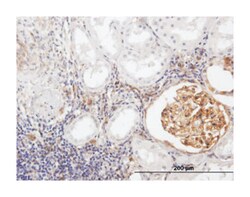
bone marrow stromal cell antigen 2, Mouse, Purified MaxPab Polyclonal Antibody,

Learn More
bone marrow stromal cell antigen 2, Mouse, Purified MaxPab™ Polyclonal Antibody, Abnova™
Mouse polyclonal antibody raised against a full-length human BST2 protein.
Brand: Abnova H00000684-B02P.50ug
Description
Bone marrow stromal cells are involved in the growth and development of B-cells. The specific function of the protein encoded by the bone marrow stromal cell antigen 2 is undetermined; however, this protein may play a role in pre-B-cell growth and in rheumatoid arthritis. [provided by RefSeq
Sequence: MASTSYDYCRVPMEDGDKRCKLLLGIGILVLLIIVILGVPLIIFTIKANSEACRDGLRAVMECRNVTHLLQQELTEAQKGFQDVEAQAATCNHTVMALMASLDAEKAQGQKKVEELEGEITTLNHKLQDASAEVERLRRENQVLSVRIADKKYYPSSQDSSSAAAPQLLIVLLGLSALLQSpecifications
| bone marrow stromal cell antigen 2 | |
| Polyclonal | |
| Mouse polyclonal antibody raised against a full-length human BST2 protein. | |
| BST2 | |
| CD317 | |
| Mouse | |
| Affinity Purified | |
| RUO | |
| Primary | |
| Human | |
| Antibody |
| Immunofluorescence, Immunohistochemistry (PFA fixed), Western Blot | |
| Unconjugated | |
| PBS with no preservative; pH 7.4 | |
| NM_004335 | |
| BST2 | |
| BST2 (NP_004326.1, 1 a.a. ∼ 180 a.a) full-length human protein. | |
| 50 μg | |
| Signal Transduction | |
| 684 | |
| Store at -20°C or lower. Aliquot to avoid repeated freezing and thawing. | |
| IgG |
Your input is important to us. Please complete this form to provide feedback related to the content on this product.